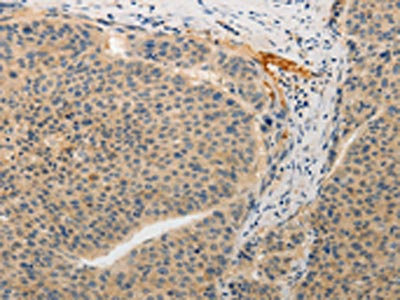

-
中文名稱:ADAMTS6兔多克隆抗體
-
貨號:CSB-PA657730
-
規格:¥1100
-
圖片:
-
The image on the left is immunohistochemistry of paraffin-embedded Human gastic cancer tissue using CSB-PA657730(ADAMTS6 Antibody) at dilution 1/15, on the right is treated with synthetic peptide. (Original magnification: ×200)
-
The image on the left is immunohistochemistry of paraffin-embedded Human liver cancer tissue using CSB-PA657730(ADAMTS6 Antibody) at dilution 1/15, on the right is treated with synthetic peptide. (Original magnification: ×200)
-
-
其他:
產品詳情
-
Uniprot No.:
-
基因名:ADAMTS6
-
別名:ADAMTS6 antibody; A disintegrin and metalloproteinase with thrombospondin motifs 6 antibody; ADAM-TS 6 antibody; ADAM-TS6 antibody; ADAMTS-6 antibody; EC 3.4.24.- antibody
-
宿主:Rabbit
-
反應種屬:Human
-
免疫原:Synthetic peptide of Human ADAMTS6
-
免疫原種屬:Homo sapiens (Human)
-
標記方式:Non-conjugated
-
抗體亞型:IgG
-
純化方式:Antigen affinity purification
-
濃度:It differs from different batches. Please contact us to confirm it.
-
保存緩沖液:-20°C, pH7.4 PBS, 0.05% NaN3, 40% Glycerol
-
產品提供形式:Liquid
-
應用范圍:ELISA,IHC
-
推薦稀釋比:
Application Recommended Dilution ELISA 1:1000-1:5000 IHC 1:15-1:50 -
Protocols:
-
儲存條件:Upon receipt, store at -20°C or -80°C. Avoid repeated freeze.
-
貨期:Basically, we can dispatch the products out in 1-3 working days after receiving your orders. Delivery time maybe differs from different purchasing way or location, please kindly consult your local distributors for specific delivery time.
-
用途:For Research Use Only. Not for use in diagnostic or therapeutic procedures.
相關產品
靶點詳情
-
基因功能參考文獻:
- Exome-chip meta-analysis identifies novel loci associated with cardiac conduction, including ADAMTS6. PMID: 30012220
- High ADAMTS-6 expression is a marker of poor prognosis in patients with esophageal squamous cell carcinoma. PMID: 29475036
- Using siRNA, over-expression and mutagenesis, it was found ADAMTS6 inhibits and ADAMTS10 is required for focal adhesions, epithelial cell-cell junction formation, and microfibril deposition. PMID: 27779234
- ADAMTS6 inhibits breast tumor development by regulating the ERK pathway via binding of miR-221-3p PMID: 27542224
- Novel inguinal hernia susceptibility genes are identified as EFEMP1, WT1, EBF2 and ADAMTS6. PMID: 26686553
- Study shows that the ADAMTS6 transcript contains unusually large untranslated regions (UTRs) at both the 5' and 3'end, and the 5'UTR contains 11 AUG codons upstream of the predicted ADAMTS6 start codon. PMID: 16129570
- The gain of function studies indicated that ADAM metallopeptidase with thrombospondin type 1 motif 6 activate NR5A1 gene expression. PMID: 18579725
顯示更多
收起更多
-
亞細胞定位:Secreted, extracellular space, extracellular matrix.
-
組織特異性:Expressed at low levels in placenta and barely detectable in a number of other tissues.
-
數據庫鏈接:
Most popular with customers
-
-
YWHAB Recombinant Monoclonal Antibody
Applications: ELISA, WB, IHC, IF, FC
Species Reactivity: Human, Mouse, Rat
-
Phospho-YAP1 (S127) Recombinant Monoclonal Antibody
Applications: ELISA, WB, IHC
Species Reactivity: Human
-
-
-
-
-